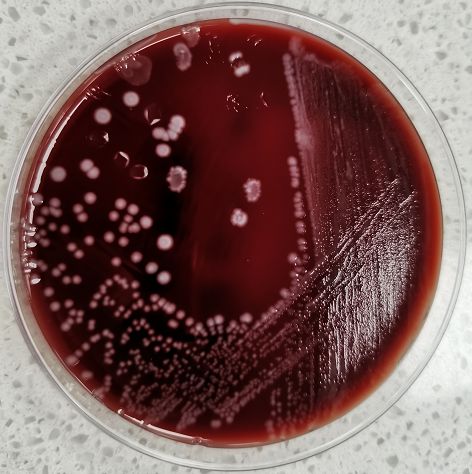
锌硒宝 药理作用(锌药片)-硒宝网

锌硒宝 药理作用(锌药片)
黑茶四宝
冠突散囊菌
属益生菌,是茯砖茶在特定温湿度条件下,通过“发花”工艺长成的自然益生菌体,俗称“金花”。在国家标准中,茯砖茶是唯一要求“冠突散囊菌”这项指标的黑茶类品种。
金花——这个地球上新发现不到30年的微生物。过去只在千年灵芝上偶尔发现过。尤其在湖南安化黑茶中的茯砖茶、千两茶中,“金花”生长极其茂密,这是安化黑茶所独有的益生菌种。

硒元素
硒被奉为“抗癌之王”,美国人防癌措施是每人每天补充200微克硒。癌症患者的血硒含量比一般人低3-6倍,更需要及时补硒。硒是癌细胞的杀伤剂,硒通过提高癌细胞中环腺甘酸的水平,形成抑制癌细胞分裂和增值的内环境。
硒含量与心血管状况密切相关,缺硒是引起心血管疾病的重要因素之一。定量补硒能?;ば募∠赴?、防止心肌纤维化,改善心室收缩的舒张性能,调整心率失常。补硒能够防止心脏的缺血缺氧性损伤。含硒的酶能消解动脉管壁损伤处聚集的胆固醇。
锗元素
锗可以抗癌,锗是有强大启动白血球作用的物质,由于白血球的辨认灵敏度提高了,癌细胞等就逃不过白血球的吞噬了。锗则可以诱发人体产生更多的干扰素,进而抵抗病毒,并防止病毒扩散或增加。锗能够使体能保持充足的氧,从而维护人体的健康。锗可均匀地分布在各器官组织中,24小时完全排出体外。
临床研究发现,锗对抗肿瘤、治疗老年痴呆、增强免疫功能、延缓衰老、预防及治疗动脉硬化、降低血液粘稠度、抗类风湿关节炎、调节内分泌、止痛消炎、降血压、治疗骨质疏松、调节内分泌、治疗慢性肝炎等方面有着显著的效果。
湖南安化黑茶中的“锗”元素的含量远远高于其他任何茶种,长期饮用黑茶,能够有效预防癌症的发生,抑制多种病变,全面提升身体的免疫力。
图冠突散囊菌

茶多糖
中国和日本民间都有用粗老茶医治糖尿病的传统。现代医学研究表明,茶多糖是茶叶治疗糖尿病时的主要药理成分。
茶多糖主要由葡萄糖、阿拉伯糖、木糖、岩藻糖、核糖、半乳糖等组成。一般来讲,原料愈粗老茶多糖含量愈高,等级低的茶叶中茶多糖含量高。在治疗糖尿病方面,粗老茶比嫩茶效果要好。
随着科技的发展,大量电器进入家庭,人们接触电磁辐射的时间越来越多,多饮茶能够预防长时间、低剂量的辐射对人体造成的危害。
另外,茶多糖还具有增强免疫功能、抗凝血、抗血栓、降血压等功能
